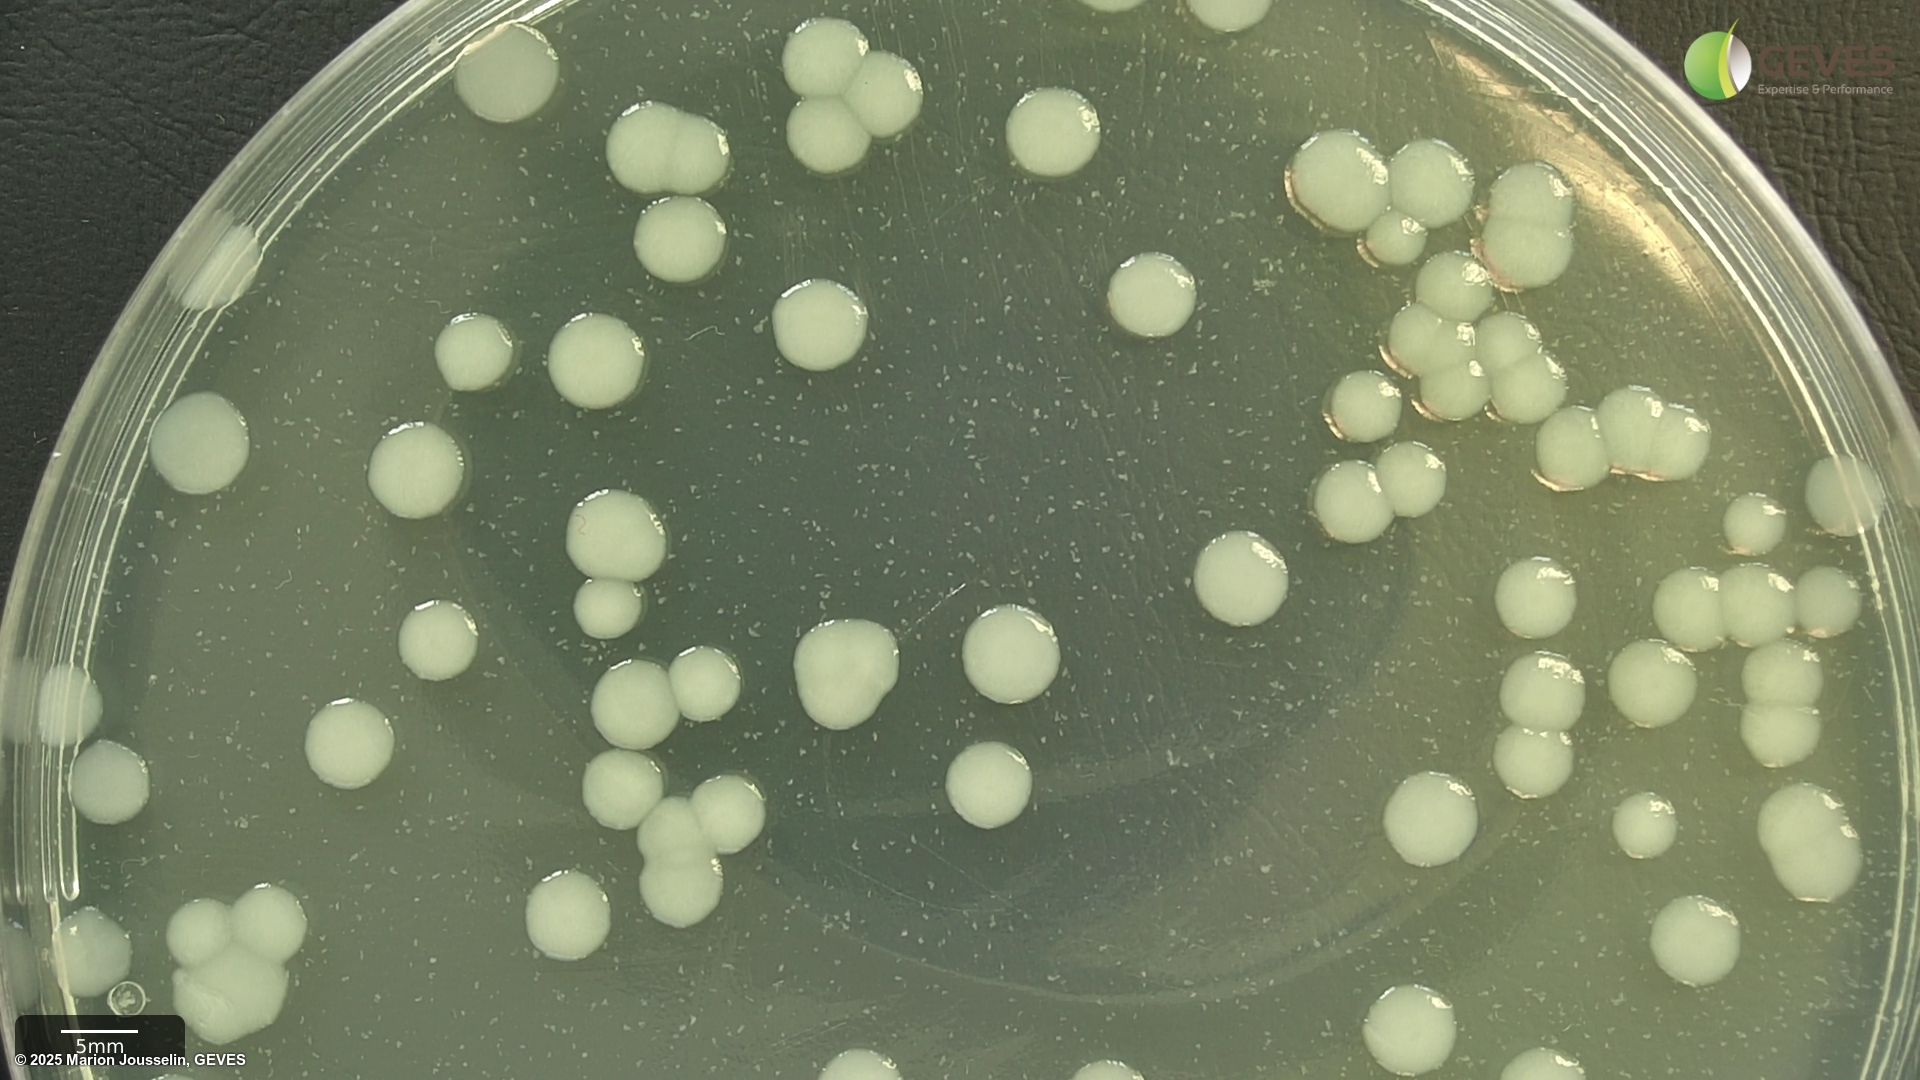
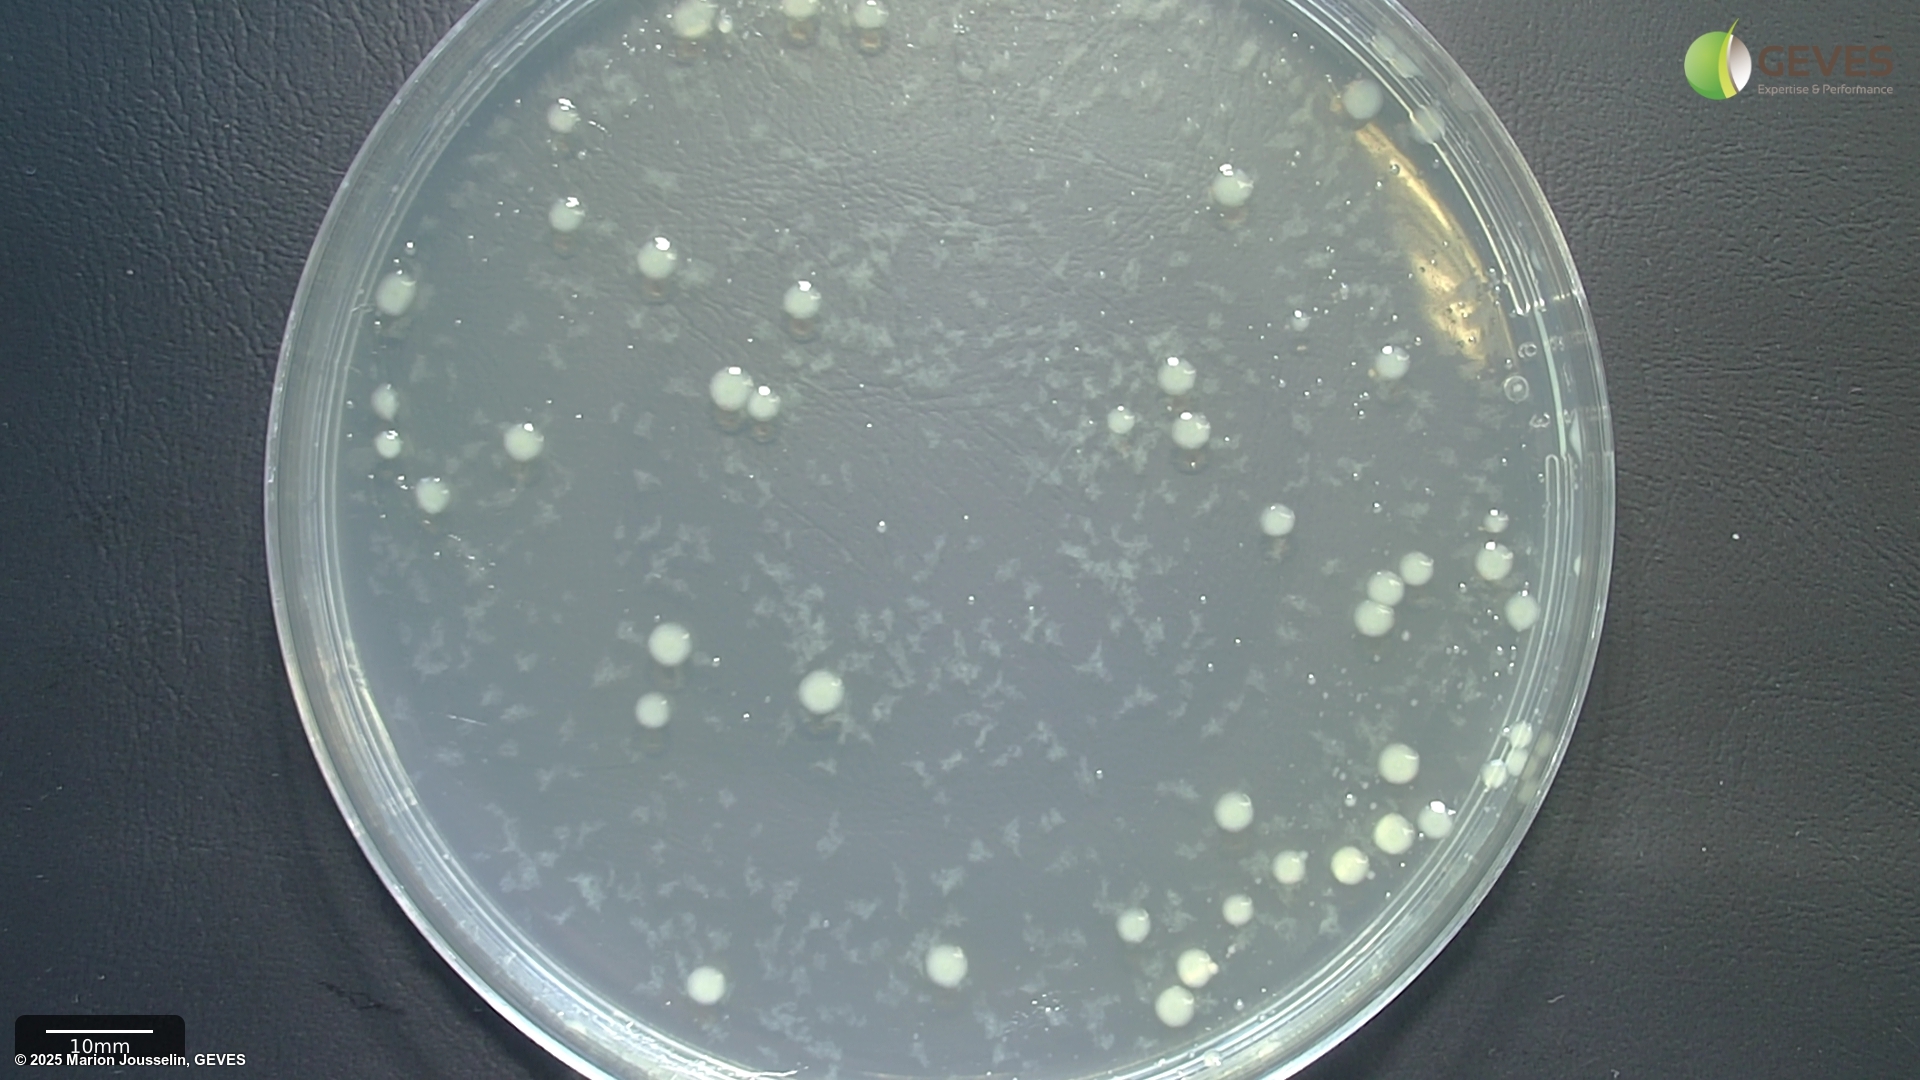
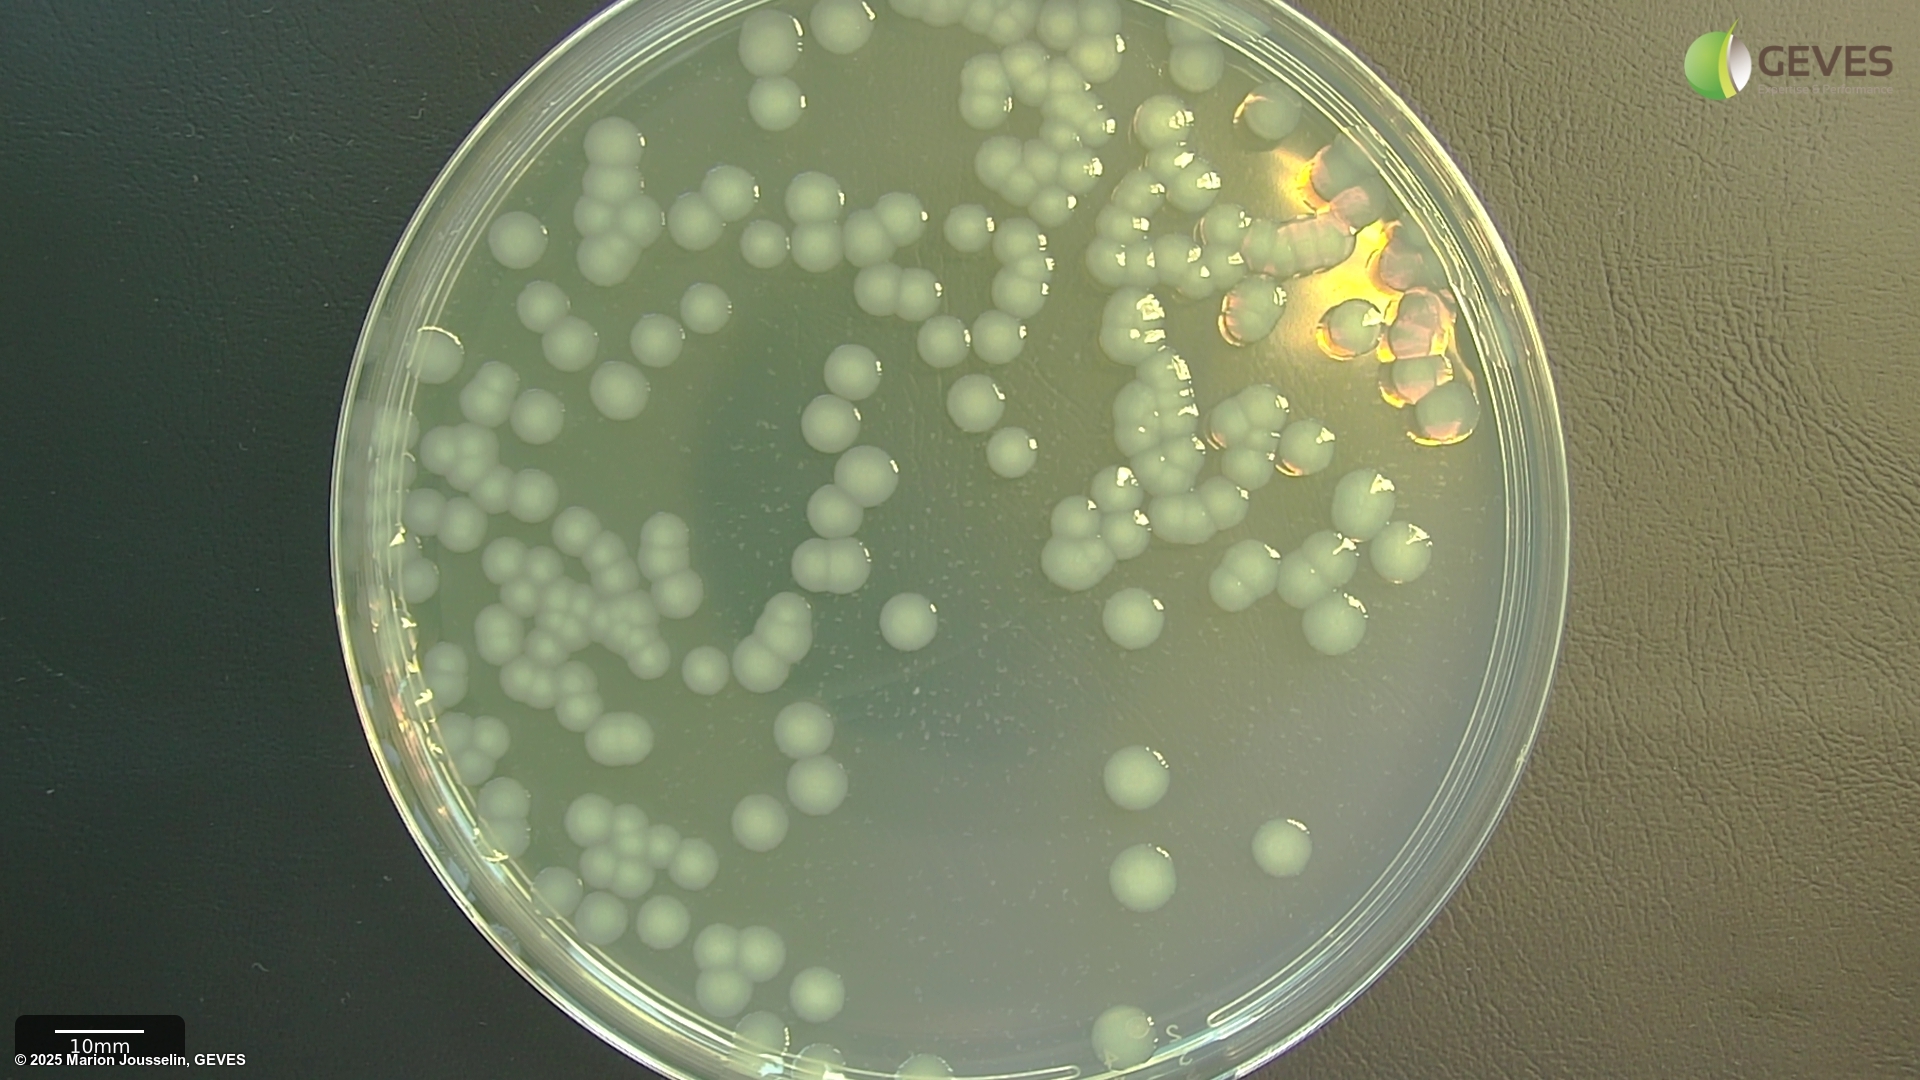
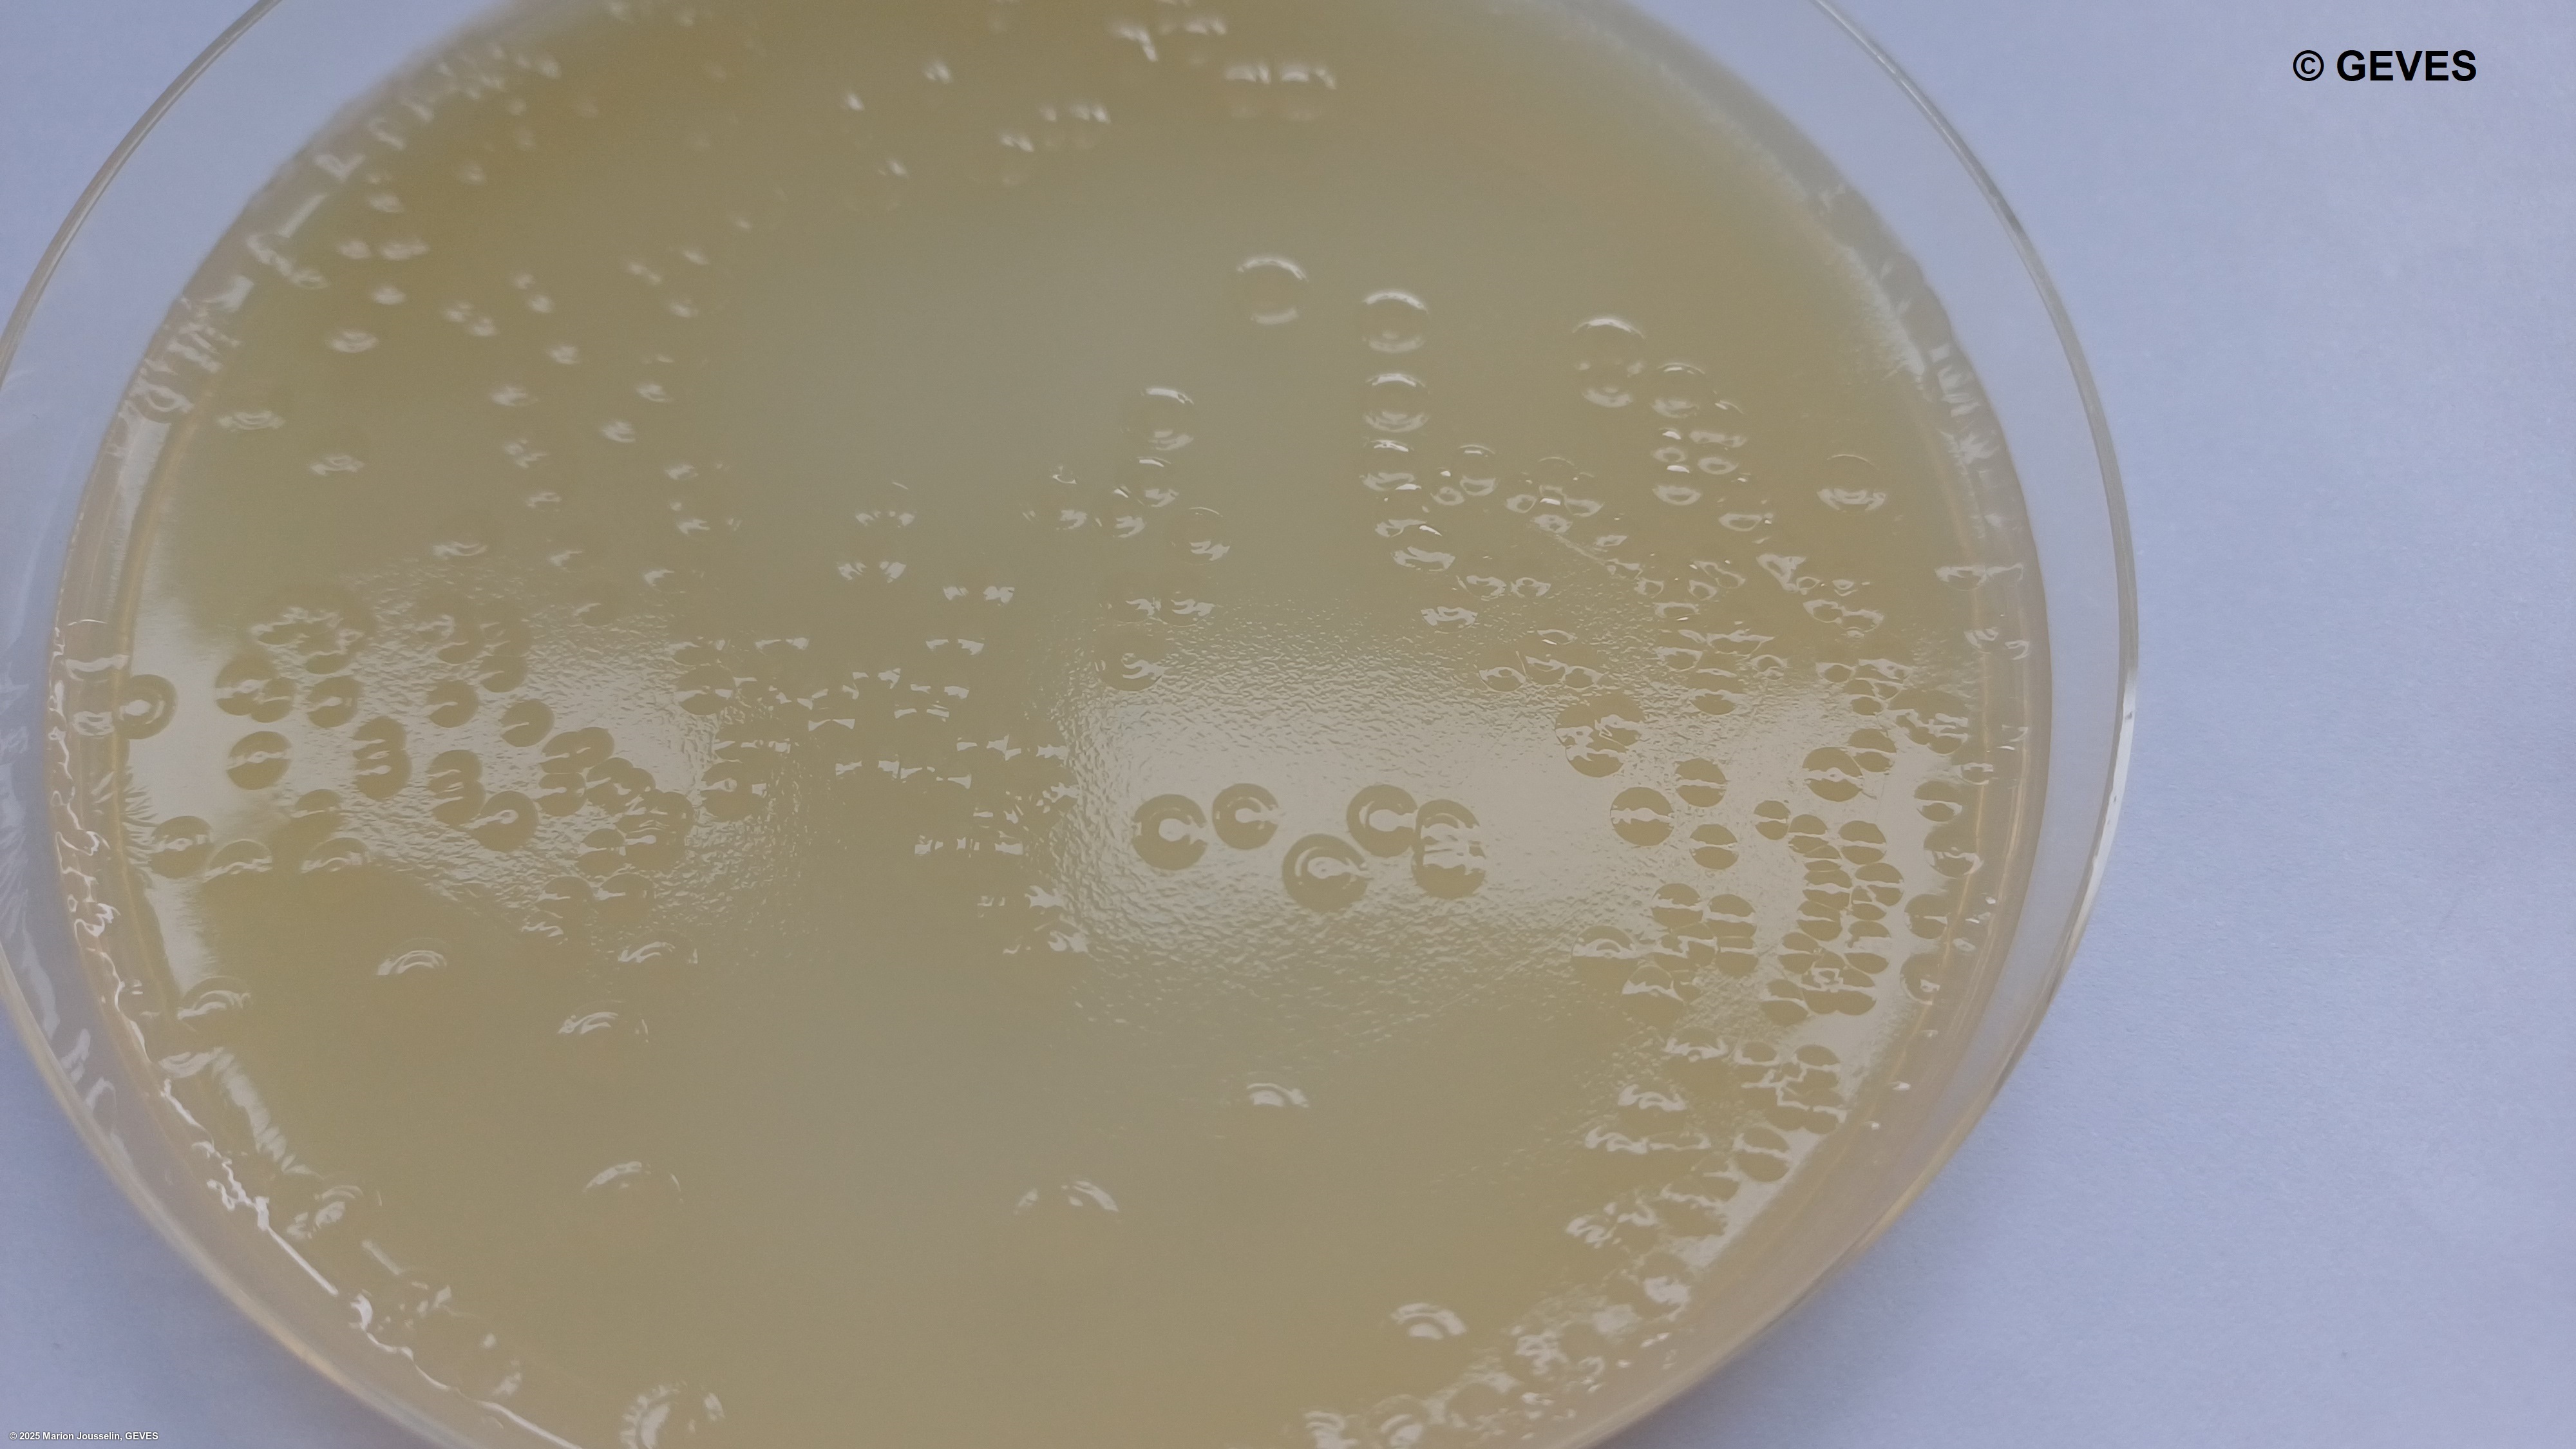

|
Triticum spp. |
Wheat |
Microdochium |
Microdochium majus |
MICDMA |
Pink snow mold |
PDA |

|
Triticum spp. |
Wheat |
Microdochium |
Microdochium majus |
MICDMA |
Pink snow mold |
PDA |

|
Triticum spp. |
Wheat |
Microdochium |
Microdochium majus |
MICDMA |
Pink snow mold |
Malt |

|
Triticum spp. |
Wheat |
Microdochium |
Microdochium nivale |
MONGNI |
Pink snow mold |
PDA |

|
Triticum spp. |
Wheat |
Microdochium |
Microdochium nivale |
MONGNI |
Pink snow mold |
PDA |

|
Beta vulgaris subsp. vulgaris |
Beet |
Neocamarosporium |
Neocamarosporium betae |
PLEOBJ |
Phoma beet spot |
PDA |

|
Beta vulgaris subsp. vulgaris |
Beet |
Neocamarosporium |
Neocamarosporium betae |
PLEOBJ |
Phoma beet spot |
Blotter paper moistened with water |

|
Beta vulgaris subsp. vulgaris |
Beet |
Neocamarosporium |
Neocamarosporium betae |
PLEOBJ |
Phoma beet spot |
Malt Agar |

|
Beta vulgaris subsp. vulgaris |
Beet |
Neocamarosporium |
Neocamarosporium betae |
PLEOBJ |
Phoma beet spot |
PDA + streptomycin |

|
Beta vulgaris subsp. vulgaris |
Beet |
Neocamarosporium |
Neocamarosporium betae |
PLEOBJ |
Phoma beet spot |
1.2% Water agar (Oxoid Technical no.3) with 2,4-D |

|
Triticum spp. |
Wheat |
Parastagonospora |
Parastagonospora nodorum |
LEPTNO |
Septoria spot blotch or Glume blotch |
PDA agar |

|
Valerianella locusta |
Corn salad |
Peronospora |
Peronospora valerianellae |
PEROVA |
Mildew |
soil |

|
Glycine max |
Soy bean |
Phomopsis |
Phomopsis longicolla |
PHOPLO |
Pod and stem blight |
ADPA |

|
Brassica spp. |
Canola |
Plenodomus |
Plenodomus biglobosus |
LEPTBG |
Avirulent or weakly virulent Blackleg |
Blotter paper moistened with water |

|
Brassica spp. |
Canola |
Plenodomus |
Plenodomus biglobosus |
LEPTBG |
Avirulent or weakly virulent Blackleg |
Blotter paper moistened with water |
|
Glycine max |
Soy bean |
Pseudomonas |
Pseudomonas savastanoi pv. glycinea |
PSDMGL |
Bacterial blight of soybean |
KBCA or LBCA |
|
Phaseolus vulgaris |
Bean |
Pseudomonas |
Pseudomonas savastanoi pv. phaseolicola |
PSDMPH |
Bacterial Blight of Bean |
KBC |
|
Glycine max |
Soy bean |
Pseudomonas |
Pseudomonas savastanoi pv. phaseolicola |
PSDMPH |
Bacterial Blight of Bean |
KBCA |
|
Phaseolus vulgaris |
Bean |
Pseudomonas |
Pseudomonas savastanoi pv. phaseolicola |
PSDMPH |
Bacterial Blight of Bean |
MT |

|
Phaseolus vulgaris |
Bean |
Pseudomonas |
Pseudomonas savastanoi pv. phaseolicola |
PSDMPH |
Bacterial Blight of Bean |
|